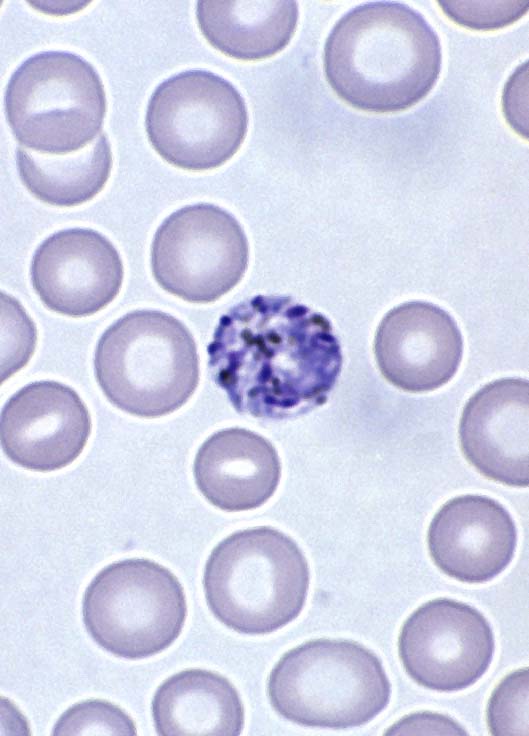
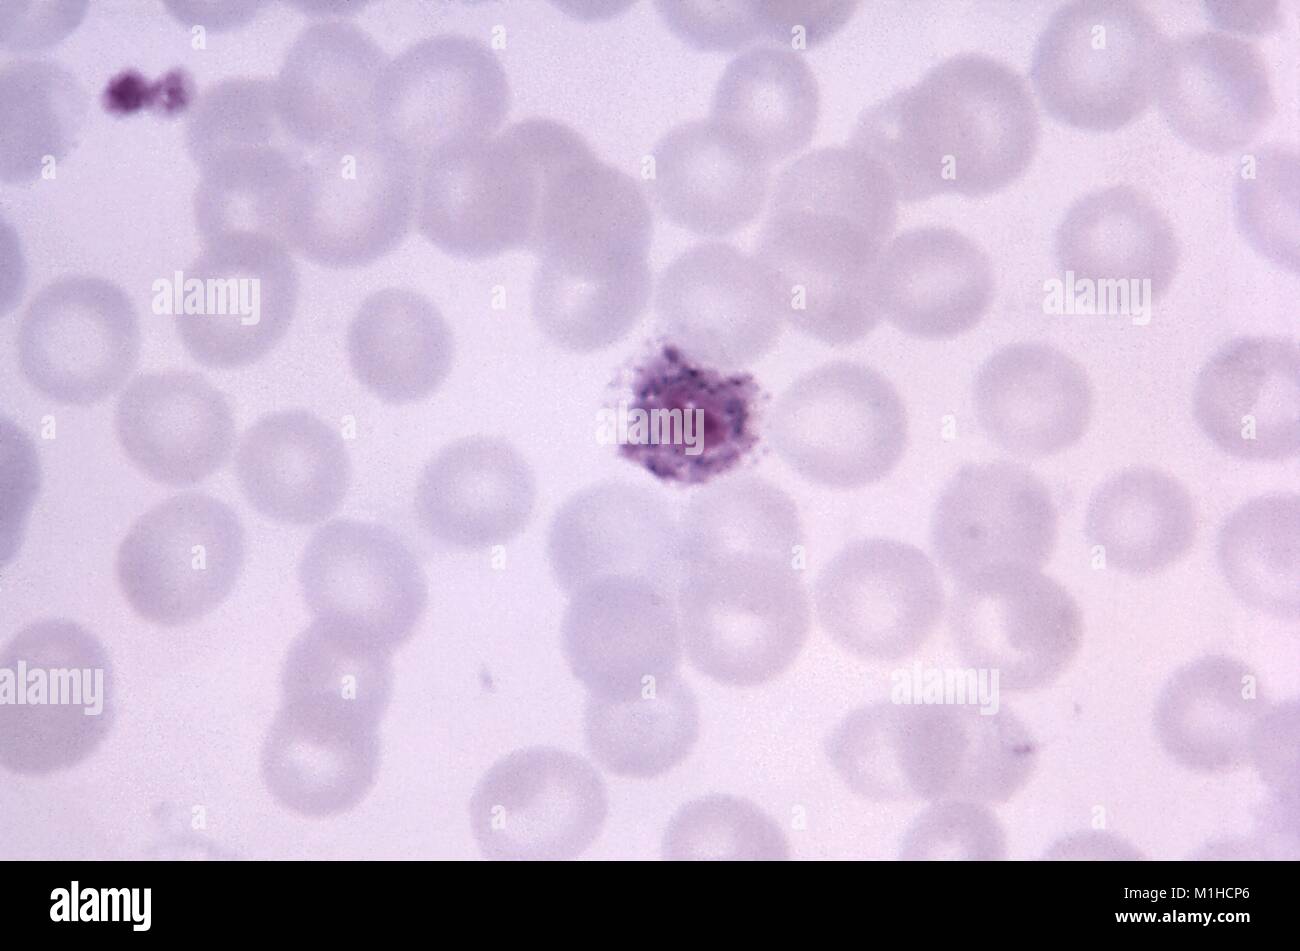
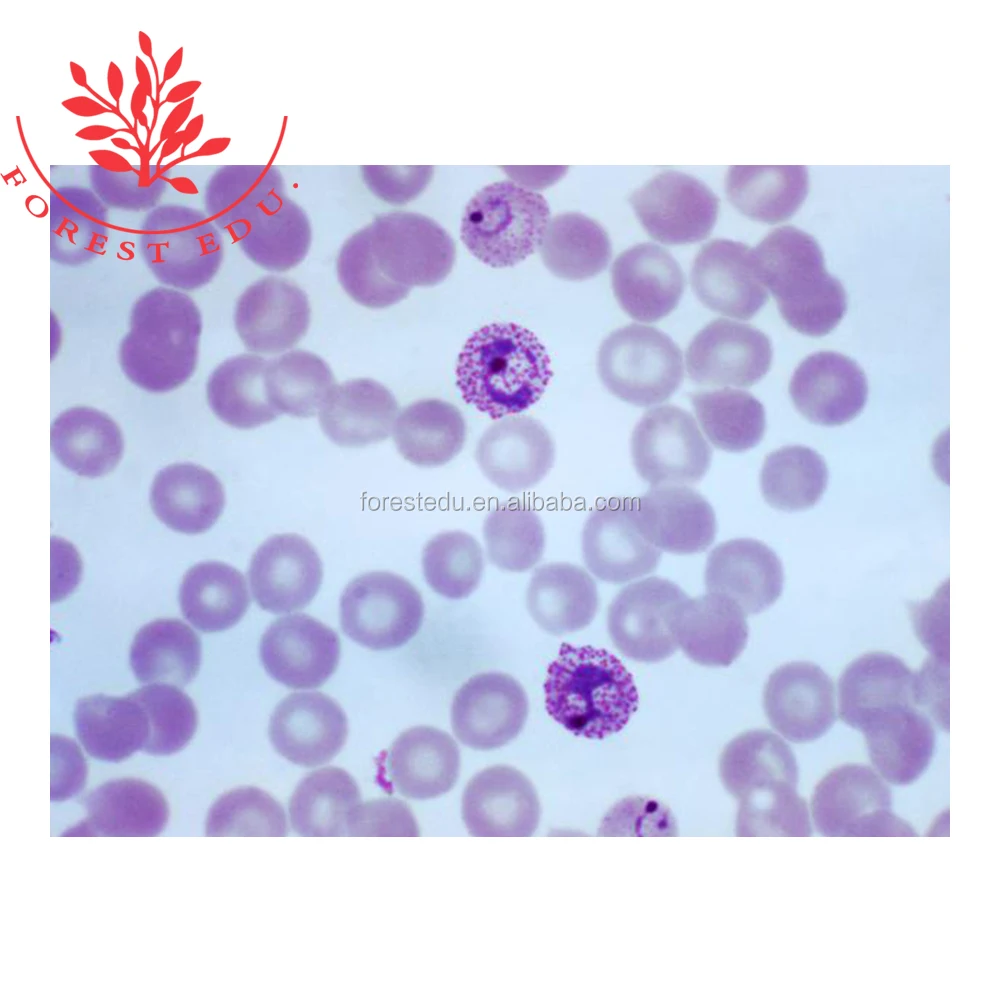

Pl vivax
Сулбой с читами
Модные одежды 2025 года
Займ пропащим финдозор август
7artisans 60mm macro
В непрозрачном мешке лежат
Проклятие масок прохождение игры
Dance your mind
Рыжая кожаная юбка
Сочинение добролюбова луч света в темном царстве
Для отмены действия используется клавиша какая
Аварийные режимы работы оборудования
Основные теории марксизма
Лекарство от заложенного носа
Pl vivax 113 фотографий